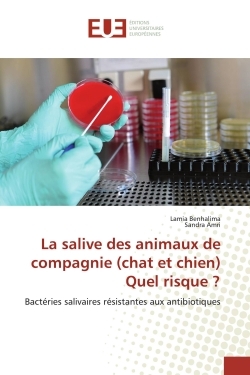
main product photo

Nous utilisons des cookies pour améliorer votre expérience. Pour nous conformer à la nouvelle directive sur la vie privée, nous devons demander votre consentement à l’utilisation de ces cookies. En savoir plus.
La salive des animaux de compagnie (chat et chien) Quel risque ?
Univ Europeenne - EAN : 9786139514250
Édition papier
EAN : 9786139514250
Paru le : 18 août 2019
54,90 €
52,04 €
Disponible
Pour connaître votre prix et commander, identifiez-vous
Notre engagement qualité
-
 Livraison gratuite
Livraison gratuite
en France sans minimum
de commande -
 Manquants maintenus
Manquants maintenus
en commande
automatiquement -
 Un interlocuteur
Un interlocuteur
unique pour toutes
vos commandes -
 Toutes les licences
Toutes les licences
numériques du marché
au tarif éditeur -
 Assistance téléphonique
Assistance téléphonique
personalisée sur le
numérique -
 Service client
Service client
Du Lundi au vendredi
de 9h à 18h
- EAN13 : 9786139514250
- Réf. éditeur : 3015551
- Editeur : Univ Europeenne
- Date Parution : 18 août 2019
- Disponibilite : Disponible
- Barème de remise : NS
- Nombre de pages : 104
- Format : H:229 mm L:152 mm E:6 mm
- Poids : 166gr
- Interdit de retour : Retour interdit
- Résumé : La salive du chat est considérée comme étant la salive la plus toxique, suivie par celle des chiens, ce sont les bactéries présentes naturellement dans cette sécrétion qui sont responsables de leur toxicité. La présente étude synthétise les données bibliographiques des principales maladies transmissibles à l'homme via la salive des animaux de compagnie, comme elle confirme, par une étude expérimentale, la présence des bactéries pathogènes antibio-résistantes dans la sécrétion salivaire des chats et des chiens domestiques.